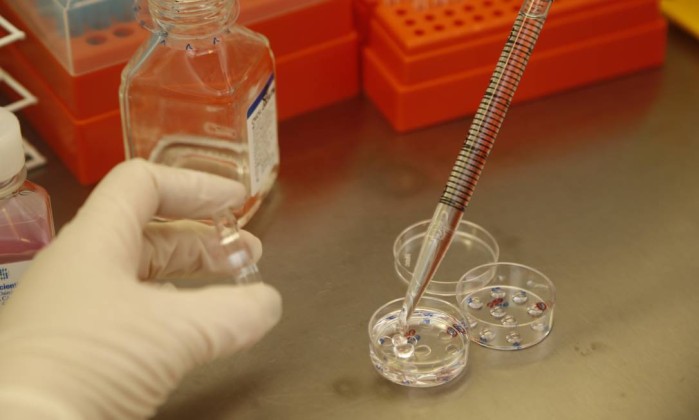

Confusão em fertilização in vitro gera dúvida sobre a paternidade dos bebês
Metade das mulheres submetidas ao tratamento de fertilidade ficaram grávidas. Algumas já deram à luz.
“Para alguns dos 26 casais, ainda há embriões congelados disponíveis, mas há o risco de que eles [também] tenham sido fertilizados pelo esperma de um homem diferente do pai pretendido”, disse o centro médico.
Segundo a instituição, os casais foram informados. Ainda não se sabe se algum deles pretende processar a clínica.
“A diretoria da UMC lamenta que os casais envolvidos tenham recebido essa notícia e fará tudo o que estiver ao seu alcance para dar clareza sobre o assunto o mais rápido possível”.
A fertilização in vitro envolve uma série de procedimentos utilizados para tratar a fertilidade ou problemas genéticos e auxiliar na concepção. Óvulos maduros são coletados dos ovários da mulher e fertilizados por esperma em um laboratório. Os óvulos fecundados são, então, implantados no útero. Um ciclo de fertilização in vitro leva cerca de duas semanas.
Não é a primeira vez que um erro assim acontece e gera repercussão. Em 2012, uma mãe de Cingapura processou uma clínica alegando negligência depois que conseguiu provar que houve mistura do esperma do marido com o de um estranho.
o globo









